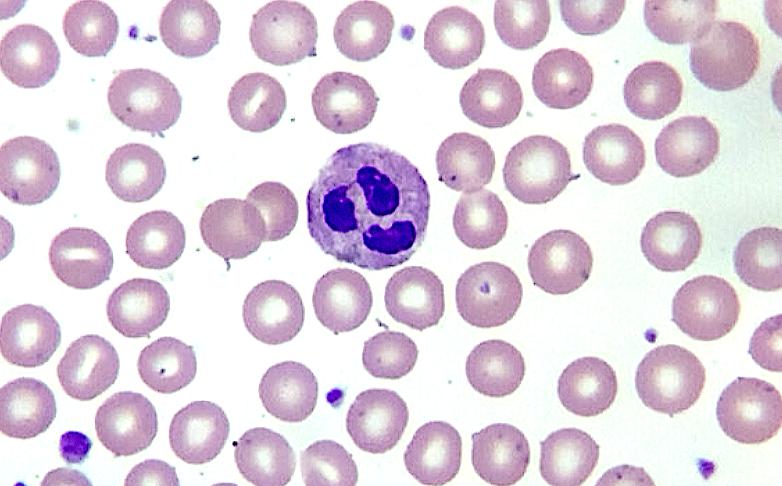
Hematology
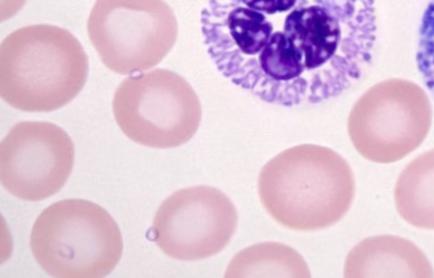
Malaria

AI-powered Microscope Automation Kit
Turn your microscope into a powerful digital diagnostic platform. Instantly digitize slides, automate analysis, and receive precise AI-powered results
Transform Your Laboratory Today
Celly's innovative iPhone-based solution converts your existing microscope into a powerful digital diagnostic platform, with real-time AI analysis that revolutionizes your workflow.
Intelligent Automation
Shift repetitive and time-consuming tasks from highly skilled pathologists to our AI system, dramatically increasing throughput while reducing fatigue and error rates.
Complete Digitalization
Access your entire slide library securely from anywhere. Expert pathologists can quickly validate results, collaborate on difficult cases, and maintain comprehensive digital records.
Clinical-Grade Analysis
Our AI algorithms have been rigorously developed with expert pathologists and validated against thousands of clinical cases, ensuring consistently accurate results that meet the highest diagnostic standards.
Simple Setup, Powerful Results
Start transforming your laboratory workflow in just three easy steps
Comprehensive Diagnostic Capabilities
Our continuously evolving AI platform supports a growing range of laboratory tests, delivering exceptional accuracy and efficiency across multiple disciplines.
Hematology
Precise automated WBC differential counts with advanced morphology recognition in blood and bone marrow smears
Malaria
Rapid parasite detection and quantification in thick and thin blood films with species identification capability
Stool Analysis
Comprehensive detection of parasites, ova, and other diagnostic indicators in stool samples with enhanced visualization
Pap Smear
AI-assisted cervical cancer screening with Bethesda classification system integration (beta version)
Histology
High-resolution digitization of tissue samples with advanced pattern recognition for pathological evaluation (beta)
Karyotyping
Automated metaphase detection for genetic testing and cytogenetic studies for high-accuracy pattern recognition
Interested in our expanding test capabilities? Join our early access program for upcoming test types including urine analysis, semen analysis, and microbiology applications.
Request AccessIntelligent Lab Solutions
State-of-the-art computer vision and machine learning algorithms that transform laboratory diagnostics
Lightning-Fast Analysis
Celly's advanced AI algorithms identify cell patterns and abnormalities in seconds, transforming hours of manual work into minutes of automated precision.
Seamless Collaboration
Access digital slides and analysis reports from anywhere, enabling real-time consultations with specialists worldwide and revolutionizing telepathology.
Enhanced Quality Assurance
Track every aspect of your microscopy workflow with comprehensive analytics, ensuring consistent results and helping maintain the highest diagnostic standards.
Powerful Teaching Platform
Build a digital repository of interesting cases for training purposes, dramatically improving educational outcomes with interactive learning experiences.
Transform Your Microscope into a Digital Pathology Platform
Instantly convert your existing microscope into a powerful digital scanner without investing in expensive specialized equipment.
Create high-resolution digital slide images that are securely stored in the cloud, enabling seamless telepathology consultations, remote diagnoses, and advanced educational opportunities.
Generate publication-quality digital images with secure cloud storage
Streamline workflow with integrated barcode scanning for perfect sample identification
Motorized Stage for Microscope: Complete Automation Solution
Transform your laboratory workflow with our motorized stage for microscope. Hands-free slide scanning and batch processing of up to 10 slides.
Seamlessly integrates with your existing microscope setup, eliminating the need for expensive dedicated slide scanners.
Automatic slide positioning - No manual alignment required
Batch processing - Scan up to 10 slides sequentially
Works with existing microscopes - No need to replace your current equipment
Choose Your Configuration
Celly motorized stage brings full microscopy automation
Pro
*Discount applies when purchasing a ready license
- Automatic Scanning
- 10 Slides
- Automatic Barcode Reading
Select Software Plan
Flexible options to meet your lab's needs
Free
- 10GB Storage
- 5 Tests/day
- Cell Atlas
Standard
- 1TB Storage
- 80 Tests/day
- LIMS Integration
- Priority Support
Enterprise
- Configurable Storage
- Unlimited Tests/day
- 24/7 Support
- Custom AI Training
Elevate Your Laboratory to the Next Level
Join the growing network of forward-thinking laboratories that have embraced AI-powered microscopy.
- Free trial with no credit card required
- Setup assistance from our team
- Full access to all features
Sign Up
Contact Us
Ready to revolutionize your laboratory? Connect with our team of experts to discover how Celly can transform your diagnostic workflow.